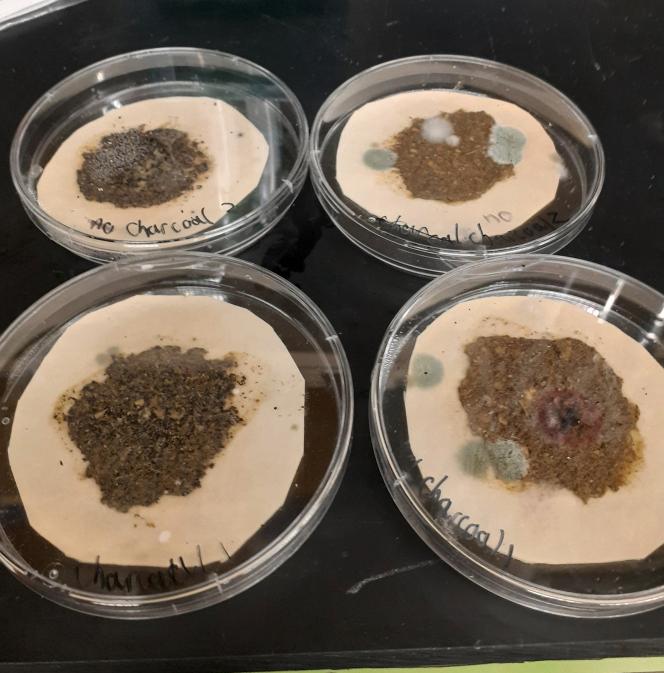
https://cdn.ncbi.nlm.nih.gov/pmc/blobs/9226/11381856/bdaa8b2aede0/gr1.jpg

一种简化的方法来获取无菌的、具有感染性的鼠旋毛虫幼虫。
A simplified protocol for deriving sterile, infectious murine Heligmosomoides polygyrus bakeri larvae.
机构信息
Department of Microbiology and Cell Biology, Montana State University, Bozeman, MT 59717, USA.
Department of Microbiology and Cell Biology, Montana State University, Bozeman, MT 59717, USA.
出版信息
STAR Protoc. 2024 Sep 20;5(3):103144. doi: 10.1016/j.xpro.2024.103144. Epub 2024 Aug 21.
Gastrointestinal helminth infection occurs within a diverse microbiome, complicating the interpretation of whether effects are caused by the parasite versus the microbial community. Here, we present a protocol for deriving sterile larvae of the murine helminth, Heligmosomoides polygyrus bakeri (H. polygyrus), providing experimental control of the microbiome. We describe steps for sterilizing with a bleach solution and developing into infectious larvae using E. coli. We then detail procedures for removing bacterial contaminants before harvesting to ensure the generation of germ-free larvae.
胃肠道蠕虫感染发生在一个多样化的微生物群中,这使得解释这些影响是由寄生虫还是微生物群落引起的变得复杂。在这里,我们提出了一种从鼠类寄生虫 Heligmosomoides polygyrus bakeri(H. polygyrus)中获得无菌幼虫的方案,为微生物组提供了实验控制。我们描述了用漂白剂溶液灭菌并使用大肠杆菌发育成感染性幼虫的步骤。然后,我们详细介绍了在收获前去除细菌污染物的程序,以确保产生无菌幼虫。